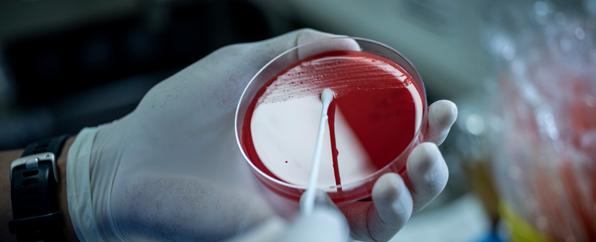

AVANÇOS E CONTRIBUIÇÕES DO CORPO
CLÍNICO EM 2024

![]()

O Hospital Erasto Gaertner é reconhecido por sua excelência no cuidado oncológico e pela constante inovação em seus serviços. Neste e-book, reunimos as principais contribuições do nosso corpo clínico ao longo de 2024, incluindo avanços científicos, pesquisas, publicações, aprimoramento tecnológico e impacto na formação de profissionais da saúde.
Este material reflete o compromisso dos nossos médicos e especialistas com a qualidade assistencial e o desenvolvimento contínuo da medicina oncológica, trazendo um panorama das conquistas que impulsionam o nosso propósito: oferecer um atendimento humanizado, seguro e inovador aos nossos pacientes. Esperamos que este conteúdo seja uma fonte de conhecimento e inspiração para todos que compartilham da missão de transformar a vida de milhares de pessoas por meio da saúde.
Equipe médica qualificada e altamente especializada em Oncologia, colocando o paciente no centro do cuidado, aliando conhecimento científico e acolhimento.
• Análises Clínicas
• Anatomia Patológica
• Anestesiologia
• Braquiterapia
• Cabeça e Pescoço
• Cardiologia
• Cirurgia Abdominal
• Cirurgia Plástica
• Cirurgia Vascular
• Clínica Médica
• Cuidados Paliativos
• Diagnóstico por Imagem
• Endocrinologia
• Fisioterapia
• Fonoaudiologia
• Genética Médica
• Ginecologia e Mama
• Hematologia e Transplante de Medula Óssea
• Hemoterapia
• Infectologia
• Neurocirurgia/Neurologia
• Oftalmologia
• Oncologia Clínica
• Ortopedia
• Pediatria
• Pele e Melanoma
• Pronto Atendimento
• Radiologia Intervencionista
• Radioterapia
• Reumatologia
• Teleterapia
• Terapia Intensiva
• Tórax
• Urologia
• Bucomaxilofacial
Confira a lista completa dos membros do Corpo Clínico do Erasto Gaertner no site: www.erastogaertner.com.br.
Acompanhando as tendências, o Hospital Erasto Gaertner realizou, em fevereiro de 2024, o primeiro exame endoscópico assistido por inteligência artificial na instituição e no Paraná (dado fornecido pelo representante da única marca liberada pela ANVISA). O procedimento consistiu em uma colonoscopia que utilizou um sistema computadorizado capaz de detectar automaticamente e em tempo real lesões com risco para câncer e pólipos intestinais. O exame foi realizado pelo Dr. Eduardo Aimoré Bonin e Dr. Leonardo Yoshio Sato, ambos médicos do Serviço de Endoscopia do HEG. Um estudo sobre a percepção e atitude dos pacientes frente a esta tecnologia está sendo conduzido e será publicado em breve.

Em outubro de 2024, o Centro de Diagnóstico por Imagem passou a contar com o tomógrafo GE Revolution EVO, que utiliza as tecnologias ASiR™ e ASiR-V™ e é capaz de emitir menos radiação sem comprometer a qualidade das imagens. O equipamento obtém imagens de alta resolução espacial de 0,28 mm, facilitando a detecção de lesões, além de fluoroscopia em tempo real para procedimentos guiados. Possui o software SmartView 3D, que melhora a precisão em biópsias, e a tecnologia AW, que reduz em até 20% o tempo de leitura dos exames, otimizando diagnósticos e acelerando tratamentos.
O Serviço de Fisioterapia concretizou dois importantes projetos em 2024. O primeiro foi a implementação da realidade virtual como aliada no tratamento fisioterapêutico na UTI cirúrgica, proporcionando uma abordagem mais interativa e eficaz. O segundo envolveu o acompanhamento fisioterapêutico e orientações domiciliares para pacientes submetidos ao transplante de medula óssea ambulatorial (TMO), garantindo um cuidado contínuo e personalizado.

Com o intuito de aumentar a precisão e a satisfação dos pacientes no manejo da dor, o Serviço de Cuidados Paliativos do Hospice Erasto Gaertner implementou novas técnicas de bloqueios anestésicos guiados por ultrassom, que permitem a injeção de anestésicos locais ao redor dos nervos ou estruturas anatômicas específicas.

O Serviço de Cirurgia Plástica do HEG se destaca como um dos maiores centros de reconstrução por microcirurgia do Brasil, utilizando técnicas de ponta adotadas pelos mais avançados centros mundiais na reparação de deformações oncológicas.
Em 2024, a equipe especializada em reconstrução de cabeça e pescoço, liderada pelos Drs. William Itikawa, Bruno Legnani e Jorge de Moraes, realizou mais de 40 retalhos microcirúrgicos. O time também ganhou reforço da Dra. Maria Cecília Closs Ono e do Dr. Alfredo Duarte da Silva, que passaram a atuar em cirurgias microcirúrgicas de reconstrução em crianças menores de 1 ano, um procedimento raro na literatura médica.
Outro avanço foi o aprimoramento no tratamento do linfedema, uma sequela oncológica que impacta a qualidade de vida dos pacientes, especialmente em casos de câncer de mama. A equipe tem utilizado supermicrocirurgia e fluorescência para mapear vasos linfáticos e realizar transplante de linfonodos, com resultados promissores. Além disso, a Dra. Anne Groth foi convidada para participar de um estudo internacional, liderado pela Universidade de Basel (Suíça), que avalia os resultados dessas cirurgias em escala global.
O Serviço também tem se dedicado ao tratamento do linfoma anaplásico de grandes células associado a implantes mamários (BIAALCL), um tipo raro de câncer que pode surgir ao redor de próteses mamárias, reforçando seu compromisso com a inovação e a excelência no atendimento.

O ano de 2024 foi marcado por avanços significativos na eficiência do uso de leitos e na redução de desperdícios, garantindo qualidade, segurança e uma excelente experiência ao paciente oncológico internado. O Serviço de Medicina Hospitalar registrou aumento de aproximadamente 10% do número médio mensal de pacientes atendidos, com redução do tempo médio de internação em 5%, mantendo uma mediana de 3 dias de internação sob responsabilidade da equipe. Além disso, os registros revelam um alto número de pedidos de consulta solicitados para a equipe (1.026), com tempo médio de resposta inferior a 24 horas.
Analisando os dados pela plataforma DRG Brasil, destacase a eficiência no uso do leito (abaixo de 100% para todos os atendimentos realizados e 89,6% quando avaliada a performance exclusiva da equipe dos médicos hospitalistas) – tendo em vista que, quanto menor o percentual, maior a eficiência e menor o desperdício. Este resultado culminou em uma economia de cerca de R$ 2,3 milhões no ano de 2024, quando comparada à média nacional de eficiência para o mesmo perfil de complexidade.
No que se refere aos atendimentos emergenciais, por meio do projeto de reconhecimento precoce de deterioração clínica e atuação do Time de Resposta Rápida, foi possível manter abaixo de 1% os atendimentos de parada cardiorrespiratória em ambiente de enfermaria.
A equipe dos médicos hospitalistas também se manteve engajada na melhoria dos processos intra-hospitalares, por meio da participação ativa em projetos de metas internacionais de segurança do paciente, comissões obrigatórias e elaboração de protocolos.
Os médicos da especialidade também desenvolveram o projeto Safety Huddle (reuniões de segurança), que consiste em encontros diários de curta duração com a equipe médica e multiprofissional, fomentando a cultura de segurança. Além disso, implementaram um projeto de análise crítica dos indicadores de eficiência operacional, recaída ou condição adquirida grave.


O Serviço de Hemoterapia, sob a liderança do Dr. João Samuel de Holanda Farias, contou com a aquisição de dois freezers para armazenamento de plasmas e crioprecipitados, o que permitiu duplicar a capacidade do estoque desses hemocomponentes, enquanto a ampliação do banco de doadores fenotipados aumentou as chances de compatibilidade para pacientes sensibilizados.
No aprimoramento de processos, a equipe implementou a Ficha de Atendimento Transfusional (FAT) online pelo Sistema Tasy, garantindo um controle mais eficiente dos registros de sinais vitais pré e póstransfusionais e eliminando o uso de fichas impressas, o que gerou economia e maior segurança nos registros.
No Laboratório de Anatomia Patológica do Hospital, a aquisição de um moderno processador de tecidos trouxe melhorias significativas para o processamento das amostras de biópsias e peças cirúrgicas. Outra contribuição relevante do Laboratório está relacionada ao encaminhamento de exames moleculares de reflexo para pacientes elegíveis.
O Serviço de Pronto Atendimento, coordenado pelo Dr. Thiago Vinicius Geisler Simioni, passou por um redimensionamento da equipe, com funções definidas e protocoladas para atender às demandas do setor; participou da aplicação de protocolos assistenciais gerenciáveis; implementou a ferramenta Safety Huddle nas passagens de plantão para aumentar a segurança assistencial; e deu início a um ciclo de aulas para aperfeiçoamento dos profissionais no atendimento aos pacientes oncológicos.

Em julho de 2024, o espaço de atendimento no ambulatório de Fisioterapia passou por uma reforma, com renovação de móveis, troca do piso, pintura das paredes, reparo das macas e instalação de espelho. A adequação e a nova organização do ambiente favoreceram a dinâmica de atendimento e trouxeram mais bem-estar aos pacientes.
Somada à melhoria da estrutura física, houve revisão dos procedimentos internos do setor. Entre eles, procedimentos de avaliação; reavaliação; fisioterapia ambulatorial; fisioterapia no pré e no pós-operatório; pré e pós-radioterapia; pré e pós-transplante de medula óssea (TMO); atendimentos de UTI e alas; tratamento de radiodermites, cicatrização de úlceras e lesões de pele; tratamento de incontinência urinária e linfedema; rotina da realização da prova de função pulmonar no pré-operatório e no pré-TMO, para definição do preparo pulmonar e profilaxia de complicações.
Além disso, a equipe de Fisioterapia da Unidade de Terapia Intensiva implementou indicadores de mobilização precoce, prevenção de pneumonia associada à ventilação mecânica (PAV) e indicadores funcionais de alta na rotina fisioterapêutica.


Em 2024, foi inaugurado o Ambulatório de Doenças Raras, coordenado pelo Serviço de Genética Médica, ampliando o acesso a diagnósticos e tratamentos especializados. Com essa nova estrutura, o hospital reforça seu compromisso em oferecer atendimento de excelência para pacientes com condições genéticas raras, consolidando-se como referência na área e proporcionando mais qualidade de vida à população.
A equipe do Serviço de Anestesiologia passou por um treinamento para utilização de um novo monitor de débito cardíaco adquirido pelo Hospital. No que se refere a novos aparelhos, a especialidade também recebeu um videolaringoscópio, dispositivo que auxilia na intubação de vias aéreas difíceis em situações críticas.
Em 2024, o Serviço de Oncologia Clínica foi responsável por números relevantes de atendimento à população. Somente pelo Sistema Único de Saúde, a equipe atendeu uma média de 140 pacientes novos por mês, registrando um total de 1.687 casos novos de câncer no ano. Somando a atuação de todos os médicos da especialidade, foram realizadas 12.927 consultas pelo SUS. A atuação da equipe de oncologistas clínicos é voltada para o tratamento sistêmico do câncer, que pode ser feito com quimioterapia, hormonioterapia ou imunoterapia. Estes tratamentos podem ocorrer de maneira isolada ou associados ao tratamento locorregional, como a cirurgia ou radioterapia. Frequentemente, os oncologistas clínicos também contribuem no diagnóstico e estadiamento do câncer, necessários para o planejamento da ação terapêutica, e no controle dos sintomas relacionados à doença ou ao tratamento.
Pela qualidade e relevância da pesquisa científica desenvolvida junto à Pontifícia Universidade Católica do Paraná, a Dra. Audrey Tieko Tsunoda, do Serviço de Ginecologia e Mama, recebeu o Prêmio de Excelência
PUC Q1. Um reconhecimento nacional e internacional pela publicação do artigo com maior fator de impacto dos Programas de Pós-Graduação
Stricto Sensu da PUCPR em 2023 e 2024, segundo o Scimago Journal
Rank Indicator. Nesta instituição de ensino, a médica também colaborou em processos de avaliação de relatórios finais e submissão de projetos de iniciação científica e tecnológica.
Juntamente com a equipe, a Dra. Audrey Tieko Tsunoda, o Dr. Reitan Ribeiro e o Dr. José Clemente Linhares, do Serviço de Ginecologia e Mama, obtiveram uma publicação no Journal of Surgical Oncology, com um artigo sobre avaliação laparoscópica do linfonodo sentinela com indocianina verde.


Dra. Audrey participou, ainda, de um estudo multinacional sobre indicadores de qualidade para avaliar os cuidados oncológicos em países de baixo e médio rendimento, pesquisa que rendeu uma publicação na The Lancet Oncology, uma das revistas científicas mais conceituadas da área da saúde. Além disso, a médica foi coautora de artigos publicados no Journal of Cancer Prevention & Current Research, International Journal of Gynecological Cancer, Nordic Journal of Music Therapy e Música Hodie.

No segundo semestre de 2024, os médicos do Serviço de Cirurgia Abdominal iniciaram um projeto de pesquisa sobre o câncer gástrico, comparando três abordagens cirúrgicas: aberta, videolaparoscópica e robótica. Paralelamente, o Dr. Flavio Tomasich e sua equipe deram início a um estudo similar, analisando essas mesmas técnicas em colectomias para tumores de cólon. Ambos os projetos, registrados no Centro de Projetos de Ensino e Pesquisa (CEPEP) do Hospital Erasto Gaertner, contribuirão para dissertações de mestrado e outras publicações científicas, ampliando o conhecimento sobre técnicas cirúrgicas oncológicas.
Com a coautoria dos professores Paulo Roberto Corsi e Luiz Carlos Von Bahten, o Dr. Flavio Tomasich foi o autor principal de um capítulo sobre diérese e síntese, que integrou o Tratado de Medicina Geral editado pela Associação Médica Brasileira. Dr. Flavio também escreveu quatro capítulos relacionados à tecnologia da cirurgia robótica para o Robotic Surgery, livro internacional publicado pela editora Elsevier, organizado pelo Dr. Stenio de Cassio Zequi, de Brasília, e pelo Dr. Hongliangi Ren, da China. Além disso, o cirurgião do HEG continuou colaborando com a análise de diferentes artigos e editoriais submetidos à revista científica do Colégio Brasileiro de Cirurgiões, publicação nacional mais qualificada atualmente na área cirúrgica, com alcance internacional.
O Serviço de Cirurgia Vascular – coordenado há 20 anos pelo Dr. Fabiano Luiz Erzinger, e atualmente composto por ele e pela Dra. Camila de Almeida Mazzoni – obteve publicações importantes para a área. Entre elas, estão as “Diretrizes sobre doença arterial periférica da Sociedade Brasileira de Angiologia e Cirurgia Vascular”, publicadas no Jornal Vascular Brasileiro, de autoria do Dr. Fabiano ao lado de mais sete colegas cirurgiões.
A partir de um relato de caso sobre colangioscopia com litotripsia biliar percutânea a laser para tratamento de cálculos biliares intra-hepáticos, o Dr. João Vitor Bacarin, do Serviço de Diagnóstico por Imagem, obteve uma publicação na revista científica Arquivos de Gastroenterologia.
Ao longo do ano, o Dr. Sanderson Cauduro, do Serviço de Cardiologia, atuou como um dos membros efetivos do Conselho de Ética em Pesquisa do HEG. Além disso, o médico contribuiu para a conclusão do Estudo SARAH, cujos resultados foram apresentados na sessão Late Breaking Clinical Trials, do American College of Cardiology, em Chicago, nos Estados Unidos. Como co-investigador, ele também deu continuidade às atividades do Estudo Cardiotox Trial, que investiga novas formas de cardioproteção durante a quimioterapia com agentes antracíclicos, e de uma pesquisa sobre câncer de mama e a importância do pré-condicionamento físico no impacto cardiovascular. Dr. Sanderson participa, ainda, do Estudo Laura, relacionado ao câncer de pulmão, liderado pela Dra. Thais Abreu, do Serviço de Oncologia Clínica.
Dr. Luiz Otavio Coelho, do Serviço de Diagnóstico por Imagem, foi o responsável pela elaboração do capítulo “Ossos Temporais”, que integra o livro “Cabeça e Pescoço”, publicado pelo Colégio Brasileiro de Radiologia e Diagnóstico por Imagem. Ele também foi um dos autores de um artigo sobre o papel da tomografia computadorizada no diagnóstico da perda auditiva neurossensorial congênita, publicado pelo periódico científico International Archives of Otorhinolaryngology. E colaborou como revisor do American Journal of Neuroradiology (AJNR).
Dr. Ronald Kool, do Serviço de Uro-Oncologia, foi um dos autores do artigo científico “Benefício da irradiação de toda a pelve para pacientes com câncer de bexiga invasivo em músculo: uma análise ponderada por probabilidade inversa de tratamento”, publicado na revista americana Journal of Clinical Oncology. O médico do HEG é o único brasileiro entre o grupo de pesquisadores do Canadá que assume autoria no artigo científico. Foi com os resultados desse trabalho, que o Dr. Ronald também se tornou o primeiro cirurgião brasileiro da história a apresentar uma plenária na ASCO-GU, congresso em oncologia que aconteceu em São Francisco (Califórnia).

Em parceria com outros colegas, Dr. Sérgio Ossamu Ioshii, Dra. Milena Massumi Kozonoe e Dra. Julia Costa Linhares, do Serviço de Anatomia Patológica, foram autores de um artigo sobre deficiência de reparo de incompatibilidade no câncer de mama bilateral, na revista Surgical and Experimental Pathology. Dr. Sérgio e Dra. Julia também fizeram parte da elaboração de um artigo sobre carcinoma lobular mamário metastático para colo uterino, na revista Mastology. Como co-autora, Dra. Julia obteve a publicação de outros quatro artigos científicos, divulgados no Jornal Brasileiro de Ginecologia, na Revista Brasileira de Cancerologia e nos periódicos Archives of Pediatric Neurosurgery e BioScience.
Com significativa atuação na produção científica, o Serviço de Cirurgia Bucomaxilofacial destacou-se pelo compartilhamento de experiências a partir de relatos de casos clínicos e técnicas utilizadas. Assim, a equipe obteve a publicação de 8 artigos em periódicos de referência, incluindo: Brazilian Journal of Health Review; Journal of Oral Diagnosis; Clinical and Experimental Dental Research e The Journal of the American Dental Association. O artigo intitulado “Avaliação da terapia de fotobiomodulação (PBMT) no fluxo e composição salivar em pacientes com câncer de cabeça e pescoço submetidos à radioterapia” foi premiado como o melhor artigo do ano pela revista Oral Surgery, Oral Medicine, Oral Pathology and Oral Radiology.
Com um capítulo sobre complicações biológicas nas reconstruções ósseas e implantes dentários após ressecções dos maxilares escrito em parceria com colegas do Brasil e dos Estados Unidos, o Dr. Laurindo Moacir Sassi, do Serviço de Cirurgia Bucomaxilofacial, contribuiu com o conteúdo do livro “Diagnóstico e tratamento das complicações em implantodontia”.
A equipe de Cirurgia Bucomaxilofacial também conquistou a publicação de 23 abstracts, resultantes de trabalhos apresentados em congressos nacionais e internacionais.
Em parceria com outros colegas, Dr. Jorge Ximenes, do Serviço de Anestesiologia, publicou um estudo experimental sobre o efeito do ácido ascórbico na lesão de isquemia e reperfusão hepática em ratos, no International Journal of Molecular Sciences.
Durante o ano, o grupo do Serviço de Cirurgia Plástica publicou capítulos de livros e artigos em revistas nacionais e internacionais de maior prestígio da especialidade, como por exemplo a Plastic and Reconstructive Surgery, da Sociedade Americana de Cirurgiões Plásticos.

Em parceria com a Scolla, o Serviço de Ginecologia e Mama realizou, em 2024, a segunda edição do curso de Imersão em Histeroscopia Diagnóstica e Cirúrgica. O Hospital Erasto Gaertner sediou a parte prática da formação, com a realização de 36 histeroscopias cirúrgicas, superando o número de procedimentos da edição anterior em tempo recorde.
O evento contou com a presença de professores e alunos do Brasil e do exterior, reunindo especialistas de diversas regiões. A iniciativa fortalece a formação de profissionais na área de histeroscopia, qualificando ginecologistas no manejo diagnóstico e cirúrgico de patologias uterinas, promovendo aprendizado e troca de conhecimentos.

Exercendo um importante papel formativo, a Dra. Audrey Tieko Tsunoda, do Serviço de Ginecologia e Mama, integrou o corpo docente de diversos cursos, incluindo a atuação como tutora na habilitação em Cirurgia Robótica do Colégio Brasileiro de Cirurgiões e o Programa de Cirurgia Robótica do Hcor.

Em 2024 aconteceu a sétima edição do “Fellowship em Cirurgia Oncológica Minimamente Invasiva do Aparelho Digestório - Cirurgia Robótica”, coordenado pelo Dr. Flavio Tomasich, do Serviço de Cirurgia Abdominal. Trata-se de um curso de um ano de duração, no qual os participantes se formam habilitados para fazer cirurgia robótica e outras tecnologias aplicadas à cirurgia oncológica.
Serviço de Cirurgia Vascular, conduziu aulas para profissionais de diferentes especialidades. Para colegas de cirurgia vascular e para ginecologistas, os temas abordados foram: “O que o ginecologista precisa saber sobre embolização de mioma uterino” e “Tratamento de miomas uterinos gigantes pela técnica de embolização”. Dr Fabiano participou, ainda, da elaboração das questões para a prova de título da especialidade da Sociedade Brasileira de Angiologia e de Cirurgia Vascular (SBACV).
O Dr. Sanderson Cauduro, do Serviço de Cardiologia, desempenhou os papeis de organizador e diretor da 13ª edição da especialização em ecocardiografia avançada, junto ao Departamento de Imagem em Cardiologia da Sociedade Brasileira de Cardiologia (SBC). Com duração de 24 meses, o curso já formou 25 cardiologistas especialistas em imagem diagnóstica em cardiologia.

Com sua formação e experiência no Serviço de Oncologia Clínica, a Dra. Tabatha Nakakogue Dallagnol assumiu a coordenação do grupo médico paranaense no Campeonato Nacional de Casos Clínicos Merck: “Aveluchampions – Celebrando a Excelência Clínica”. O programa médico-científico reuniu especialistas de todo o Brasil em eventos e reuniões para discutir o tratamento do Carcinoma Urotelial (UC).
Além da Dra. Tabatha, o Dr. Ronald Kool, do Serviço de Uro-Oncologia do HEG, também participa da iniciativa. O projeto foi lançado em abril de 2024, durante o 15º Congresso Internacional de Uro-Oncologia, e a divulgação dos resultados está prevista para março de 2025.
Dra. Tabatha também contribuiu na pós-graduação em Farmácia Oncológica da Pontifícia Universidade Católica do Paraná (PUCPR), com aulas sobre os princípios de oncologia clínica e estadiamento; recursos diagnósticos em oncologia; review de tumores de cabeça e pescoço.

Por meio do trabalho intitulado “Otimização do uso do leito hospitalar e impactos financeiros com a implantação de equipe de Medicina Hospitalar de alta complexidade”, os resultados positivos alcançados pelo time dos hospitalistas foram apresentados durante o 11° Encontro de Saúde Coletiva de Curitiba, em reconhecimento pelas boas práticas adotadas no HEG.
Além disso, os médicos do Serviço de Medicina Hospitalar também iniciaram atividade docente junto aos acadêmicos do internato de Medicina da Universidade Positivo, nos estágios de clínica médica e emergências.
Em atividade de capacitação promovida pela Sociedade Brasileira de Medicina Nuclear, em Curitiba (PR), o Dr. João Vitor Bacarin, do Serviço de Diagnóstico por Imagem, foi um dos palestrantes do curso hands on intitulado “Teranóstico em câncer de próstata”, com 24h de duração.
Compartilhando seus conhecimentos sobre neurologia e dor e sua experiência no Serviço de Cuidados Paliativos, o Dr. Bruno Bertoli Esmanhotto ministrou aulas na pós-graduação em dor do Instituto de Ensino Albert Einstein. E pela dedicação ao ensino, Dr. Bruno foi professor homenageado do curso de Medicina da Faculdade Pequeno Príncipe.
Em 2024, o Serviço de Endoscopia Terapêutica recebeu dois médicos de Belo Horizonte (MG) para treinamento de técnicas de ecoendoscopia e tratamento endoscópico de câncer digestivo precoce, um programa de ensino oferecido pela instituição que vem se destacando no Sul do Brasil.

O Dr. Laurindo Moacir Sassi e o Dr. Fernando Zanferrafi, do Serviço de Cirurgia Bucomaxilofacial estiveram presentes em dez bancas ao longo do ano, incluindo trabalhos de conclusão de curso, mestrado e residência.
O Dr. Jorge Luiz Saraiva Ximenes, do Serviço de Anestesiologia do HEG, atuou como professor e coordenador do curso “Manejo do Sangramento no Perioperatório”, promovido pela Sociedade Paranaense de Anestesiologia. O curso também contou com a participação do Dr. Tiago Galvão Feronato como instrutor, reforçando o compromisso dos especialistas com a qualificação contínua na área.
Além de ministrarem aulas para acadêmicos de Medicina em diversas universidades, os especialistas do Serviço de Cirurgia Plástica também atuaram na formação do Fellowship em Microcirurgia e Cirurgia Plástica Reparadora em Oncologia, oferecido pelo HEG. Entre os destaques, a Dra. Renata Marcante concluiu seu treinamento, participando de centenas de casos complexos de reconstrução oncológica.

Ao longo de 2024, o Dr. Flavio Tomasich, do Serviço de Cirurgia Abdominal, compartilhou seu conhecimento em diversos eventos científicos. No Cirurgião Ano 14, promovido pela Faculdade de Medicina da USP, no Hospital das Clínicas de São Paulo, ministrou uma palestra sobre cirurgia robótica e câncer de cólon e participou de duas mesasredondas como debatedor.
No 24º Congresso Paulista de Cirurgia, organizado pela Sociedade Paulista de Cirurgia e pelo Colégio Brasileiro de Cirurgia – Capítulo de São Paulo, integrou duas mesas-redondas, abordando nutrição e preparo pré-operatório, além da linha de cuidados em oncologia e cirurgia do aparelho digestivo. Já no 30º Suespar (Simpósio das Unimeds do Estado do Paraná), em Foz do Iguaçu (PR), participou de discussões sobre o sistema cooperativo e o atendimento de doenças específicas, ampliando o debate sobre temas estratégicos na área da saúde.
O médico representou o corpo clínico do HEG como palestrante e debatedor no 22º Congresso Brasileiro de Cirurgia, no Rio de Janeiro, onde abordou temas relacionados à cirurgia oncológica e reconstrução.
Também participou do 4º Congresso Brasileiro de Cirurgia do Aparelho Digestivo (Oncogi) e do 1º Congresso Sul-Brasileiro de Cirurgia Oncológica, em Florianópolis (SC), ministrando uma palestra sobre tumores do estômago e abordagem robótica.

A Dra. Audrey Tieko Tsunoda, do Serviço de Ginecologia e Mama, participou de cursos sobre cirurgia ginecológica geral laparoscópica (Ircad América Latina), tratamento do câncer ginecológico e cirurgia de resgate na recidiva do câncer de ovário (Adium), papel da robótica no manejo do câncer de ovário inicial, anatomia vascular e linfática pelo olhar da cirurgia robótica e abordagem do câncer do colo do útero inicial e na gestação (Hospital Israelita Albert Einstein).
Ela também participou de eventos científicos de referência no Brasil e fora do país, tais como: 9ª ENDO Dubai, nos Emirados Árabes Unidos; 33º ESGE Congress, em Marselha, na França; Encontro Anual da Sociedade Internacional de Câncer Ginecológico (IGCS), em Dublin,
na Irlanda (no qual também atuou como diretora); MIGS 2024 e 7º Simpósio Nacional EVA de Tumores Ginecológicos, em São Paulo (SP); 2º Congresso Sul Brasileiro de Oncoginecologia da Santa Casa de Porto Alegre (RS); Congresso Brasileiro de Câncer na Mulher (4º Congresso Brasileiro de Oncoginecologia e 2º Congresso Brasileiro de Neoplasias das Mamas), no Rio de Janeiro (RJ); e 1º Congresso Sul-Brasileiro de Cirurgia Oncológica 2024, em Florianópolis (SC).

Dr. Fabiano Erzinger, do Serviço de Cirurgia Vascular, fez parte da organização do 45º Congresso Brasileiro de Angiologia e Cirurgia Vascular, o maior evento da especialidade na América Latina, que em 2024 aconteceu em Foz do Iguaçu (PR). Na ocasião, ele ministrou palestras sobre as diretrizes relacionadas à doença arterial periférica dos membros inferiores e sobre a importância da utilização de meia elástica em casos de síndrome pós-trombótica. Também foi coordenador e palestrante de uma mesa-redonda que abordou a terapia regenerativa em cirurgia vascular, apresentando evidências científicas desse tipo de terapia em pacientes com pé diabético.
No 79º Congresso Brasileiro de Cardiologia, organizado pela Sociedade Brasileira de Cardiologia e realizado em Brasília (DF), o Dr. Sanderson Cauduro, do Serviço de Cardiologia, foi um dos convidados que colaboraram na análise de trabalhos científicos recebidos pelo evento.

Os especialistas do Serviço de Oncologia Clínica marcaram presença em importantes eventos nacionais e internacionais de aprimoramento. Entre eles, o 25º Congresso Brasileiro de Oncologia Clínica, realizado no Rio de Janeiro (RJ) e promovido pela Sociedade Brasileira de Oncologia Clínica (SBOC).
Dra. Tabatha Nakakogue Dallagnol participou do Congresso da Sociedade Americana de Oncologia - Divisão Genitourinária (ASCO GU 2024), em São Francisco (EUA), e o 15º Congresso Internacional de Uro-Oncologia, em São Paulo (SP). Também fez parte da programação de evento científico online simultâneo ao Congresso da Sociedade Europeia de Oncologia Clínica (ESMO 2024), em Barcelona (Espanha), com apresentação e discussão de
casos clínicos focados em câncer de próstata. Além disso, ficou a cargo da Dra. Tabatha a coordenação e a moderação do Módulo Genitourinário do 4º Moonshot - Congresso Internacional do IOP, realizado em Curitiba (PR).
Para aprofundar os estudos na área do câncer de mama, Dr. Fabricio Augusto Martinelli de Oliveira, do Serviço de Oncologia Clínica do HEG, foi um dos participantes da 13ª edição do Brazilian Breast Cancer Symposium, em Brasília (DF). Como congressista, o médico esteve em Cartagena, na Colômbia, durante o Onconnecta LATAM 2024 Summit, evento científico dedicado ao câncer de próstata. O médico ainda esteve presente no 15º Congresso Internacional de Uro-Oncologia e no 10º Simpósio Multiprofissional de Uro-Oncologia, realizados simultaneamente em São Paulo (SP).
Já o Dr. João Soares Nunes apresentou trabalho em evento da Sociedade Americana de Oncologia Clínica (ASCO), em Chicago (EUA).

Representando o Serviço de Hemoterapia do HEG, o Dr. João Samuel de Holanda Farias, duas analistas e a supervisora do setor participaram do Congresso Brasileiro de Hematologia e Hemoterapia (HEMO 2024), em São Paulo (SP).

Dra. Milena Massumi Kozonoe, do Serviço de Anatomia Patológica, participou de diversos eventos de aprimoramento, incluindo: 34º Congresso Brasileiro de Patologia, em Belém (PA); 4º MoonshotCongresso Internacional do IOP (participação como moderadora da mesa sobre hematologia) e curso Up to Date Hematologia, em Curitiba (PR). Ela também fez parte de um seleto grupo de 40 patologistas que receberam um treinamento sobre o exame HER2-pan tumor, na Rede D’Or, em São Paulo (SP). E realizou curso de atualização com foco em uropatologia, ministrado pelo Prof. Dr. Athanase Billis.
Com sete trabalhos apresentados, a Dra. Julia Costa Linhares (Serviço de Anatomia Patológica) participou ativamente do 34º Congresso Brasileiro de Patologia e do 27º Congresso Brasileiro de Citopatologia, em Belém (PA). A médica também ministrou aula e integrou uma mesaredonda no 12º Paraná Colposcopia, em Curitiba (PR).
Em relação à capacitação interna, a equipe do Serviço de Medicina Hospitalar participou de congressos voltados à melhoria do cuidado, qualidade e segurança. A Dra. Bruna Fornazari concluiu a especialização em dor pela Universidade de São Paulo, recebeu o título de especialista em Medicina Paliativa pela Associação Médica Brasileira, compôs a
equipe da Qualidade do HEG, presidiu a Comissão de Revisão de Prontuários da instituição e permanece como preceptora da residência de Clínica Médica do Hospital de Clínicas da UFPR.
O Dr. Vitor Guimarães de Macedo concluiu a pós-graduação em Gestão da Qualidade e Segurança nas Organizações de Saúde pela Faculdade Israelita de Ciências da Saúde Albert Einstein. Ele contribuiu como palestrante do 19° Congresso Paranaense de Clínica Médica com o tema da Síndrome Consumptiva, participou do 5° Congresso Brasileiro de Medicina Hospitalar, realizou atualização no Programa de Suporte Avançado de Vida Cardiovascular (SAVC) da American Heart Association pela PUCPR e, além disso, compôs a equipe médica da Qualidade e segue como preceptor da residência de Clínica Médica do Hospital de Clínicas da UFPR.
A Dra. Letícia Cabrini deu seguimento às atividades no programa de Mestrado Profissional em Oncologia no A.C. Camargo Cancer Center, com conclusão prevista para 2025. E iniciou atividades como preceptora da residência de Clínica Médica da PUCPR.
O Dr. Matheus Plazza presidiu a Comissão de Óbitos do HEG e concluiu o Programa de Qualificação Multiprofissional em Segurança do Paciente do Instituto Brasileiro de Segurança do Paciente.

O Dr. João Vitor Bacarin, do Serviço de Diagnóstico por Imagem, participou ativamente de eventos científicos de destaque ao longo do ano. No 41º Congresso Brasileiro de Pneumologia e Tisiologia, realizado junto ao 17º Congresso Brasileiro de Endoscopia Respiratória e ao 13º Congresso Luso-Brasileiro de Pneumologia, em Florianópolis (SC), integrou uma mesa-redonda sobre multidisciplinaridade nas neoplasias pulmonares, ministrando uma aula sobre radiologia no apoio ao diagnóstico.
No 27º Congresso da Sociedade Brasileira de Radiologia Intervencionista e Cirurgia Endovascular (SOBRICE), em São Paulo (SP), teve um trabalho apresentado como pôster, em coautoria com outros colegas, sobre marcação de nódulos pulmonares com mistura de azul de metileno e espuma hemostática. Também atuou como debatedor no bloco sobre cólon, reto e canal anal na 2ª edição do GI Update Curitiba.
Além disso, foi palestrante no 1º Simpósio de Câncer de Pulmão do Erasto Gaertner e no 4º Moonshot – Congresso Internacional do IOP. Para aprofundar seus conhecimentos, participou ainda da Imersão em Intervenção Linfática, promovida pelo IRCAD América Latina, no Rio de Janeiro (RJ).

O Dr. Luiz Otavio Coelho, do Serviço de Diagnóstico por Imagem, compartilhou seu conhecimento como palestrante em importantes eventos da especialidade ao longo de 2024. No Atualiza24, curso anual do Colégio Brasileiro de Radiologia, conduziu o módulo de Cabeça e Pescoço, abordando malformações dos ossos temporais.
No 53º Congresso Brasileiro de Radiologia e Diagnóstico por Imagem, em Salvador (BA), ministrou palestras sobre linfonodos cervicais, avaliação por imagem dos procedimentos estéticos e hipoacusia condutiva. Já na Jornada Paranaense de Radiologia 2024, discutiu a avaliação por imagem do zumbido. Também participou do Clube do Interior da Sociedade de Radiologia do Paraná, onde abordou múltiplos temas de imagem em cabeça e pescoço.
A fisioterapeuta Gisele Assunção participou do 3º Congresso Online da ABRAFITO (Associação Brasileira de Fisioterapia Traumato-Ortopédica) e do 4º Moonshot – Congresso Internacional do IOP. Além disso, concluiu um curso sobre cuidados paliativos em oncologia pela plataforma Onco Ensino, com apoio do Instituto de Ensino e Pesquisa Albert Einstein. Já a fisioterapeuta Elizabeth Hidemi Otani aprimorou seus conhecimentos com cursos online de reabilitação vestibular e neurociência da dor.

A Dra. Clarice Nana Yamanouchi, do Serviço de Cuidados Paliativos, foi palestrante do 30º Simpósio das Unimeds do Estado do Paraná (Suespar) e do 11º Encontro de Saúde Coletiva de Curitiba.
O Dr. Luiz Sérgio Batista II, do Serviço de Medicina Hospitalar, participou do 5º Congresso Brasileiro de Medicina Hospitalar, em Porto Alegre (RS), e foi coautor de um pôster apresentado no 10º Congresso Brasileiro de Cuidados Paliativos, em Fortaleza (CE). Neste mesmo congresso, também estiveram presentes os Drs. Ana Beatriz Rocha Bettega, Bruna Fontoura, Manoela Mario Martins, Renata Bueno e Edek Francisco de Mattos da Luz, reforçando a atuação da equipe na área de cuidados paliativos. Dra. Renata, Dra. Manoela, Dra. Ana Beatriz e Dr. Edek também participaram do 1º Congresso Nacional Interdisciplinar de Cuidados Paliativos (CONICUP), realizado na modalidade online.

Dr. Bruno Bertoli Esmanhotto (Serviço de Cuidados Paliativos) ministrou aula na segunda edição do National Pain Symposium, realizado em Balneário Camboriú (SC), durante o 56º Congresso Brasileiro de Farmacologia e Terapia Experimental. Também conduziu uma aula sobre dor no Simpósio de Feridas do Hospital Dermatológico São Roque, em Piraquara (PR).
A Liga Acadêmica de Cuidados Paliativos do Hospital Erasto Gaertner teve um livro publicado em 2024. O e-book chamado “Manual Acadêmico de Cuidados Paliativos” fornece aos acadêmicos interessados em cuidados paliativos um panorama multiprofissional sobre os principais temas da área.
Em 2024, o Dr. Deivid Calebe de Souza, integrante do Serviço de Genética Médica do HEG, foi o único candidato das Américas selecionado para o ESHG International Mentorship Programme, da Sociedade Europeia de Genética Humana. A mentoria junto ao Dr. Etienne Rouleau foi vivenciada no Instituto Gustave Roussy, terceiro melhor hospital do mundo em oncologia, localizado em Villejuif, na França. Neste ano, o Dr. Deivid também concluiu fellowship em oncogenética pelo Hospital Sírio-Libanês, em São Paulo (SP).
Somando as atividades do 50º Congresso Brasileiro de Estomatologia e Patologia Oral, em São Paulo (SP), do 26º Congresso Brasileiro de Cirurgia e Traumatologia Bucomaxilofacial, em Belém (PA), e do 10º Congresso Sul-Brasileiro de Câncer Bucal, em Porto Alegre (RS), o Serviço de Cirurgia Bucomaxilofacial apresentou um total de 20 trabalhos nos principais eventos científicos de 2024, além da participação como congressistas. No evento realizado na capital gaúcha, o estudo “Vestibuloplastia para correção de sequela cirúrgica pós-glossectomia parcial” recebeu menção honrosa na categoria de relatos de casos. A equipe também foi responsável por 29 palestras e mentorias ao longo do período.
No Hospital Sírio Libanês, em São Paulo (SP), o cirurgiãodentista Fernando Zanferrari participou do 12º Curso Prático de Artroscopia Articulação Temporomandibular (ATM) e da formação Grand Rounds - Cabeça e Pescoço com o tema “CEC de Cavidade Oral”. No A.C. Camargo Cancer Center, ele participou de curso livre de diagnóstico por imagem em oncologia.

Com o trabalho intitulado “Crise hipertensiva durante ressecção de tumor retroperitoneal: paraganglioma não identificado. Vale a pena fazer a triagem?”, a Dra. Berenice Maria Kominek Sato e o Dr. Jorge Luiz Saraiva Ximenes representaram o Serviço de Anestesiologia do HEG em uma das sessões de apresentação no The Anesthesiology Annual Meeting, evento da Sociedade Americana de Anestesiologistas, realizado na Filadélfia (EUA). Na mesma ocasião, a Dra. Patricia Moreira e o Dr. Tiago Galvão Feronato apresentaram um relato de caso com uma abordagem inovadora para manejo da anestesia na mastectomia robótica.
Com o tema “Hemoterapia em pacientes ‘contrários’ – em que momento estamos?”, o anestesiologista Dr. Jorge Luiz Saraiva Ximenes compôs o time de palestrantes da 57ª Jornada Sul-Brasileira de Anestesiologia, em Curitiba (PR). Ele também ministrou aula em webinar promovido pela Sociedade Brasileira de Anestesiologia, sobre anestesia para transplantes, abordando aspectos legais, farmacologia de imunossupressores, cuidado com doadores e particularidades do paciente pediátrico.
No 20º Congresso Paulista de Anestesiologia (COPA 2024) e no 24º Congresso Mundial de Anestesia Oftalmológica (WCOA 2024), realizados em São Paulo (SP), a Dra. Patricia Moreira, a Dra. Berenice Sato, a Dra. Marina Lopes Ferreira e outros colegas apresentaram um relato de caso sobre reação alérgica após uso de indocianina verde em paciente com histórico de alergia a iodo. Também participaram como congressistas desses eventos as anestesiologistas Dra. Ana Carolina Lemos Perrini, Dra. Samara Vaz Carneiro e Dra. Melina Pampuch Metzger.

Dr. Jorge de Moraes, do Serviço de Cirurgia Plástica, realizou fellowship em reconstrução de mama no Pius-Hospital Oldenburg, na Alemanha.

Durante o 9th International Breast Surgery Workshop e 5th World Consensus Conference on BIA-ALCL, em Roma, na Itália, a cirurgiã plástica Dra. Anne Groth apresentou os resultados do tratamento de pacientes brasileiros com linfoma anaplásico de grandes células associado a implantes mamários.
Dr. Alfredo Duarte da Silva fez parte da organização do 38º Congresso Científico dos Acadêmicos de Medicina (CONCIAM), promovido pela Universidade Evangélica Mackenzie do Paraná. Na ocasião, o Dr. Bruno Pieri palestrou sobre supermicrocirurgia e tratamento cirúrgico do linfedema. O Dr. Bruno também foi palestrante no 3º Curso de Extensão em Microcirurgia – Reconstrução de Mama da UFPR, abordando a reconstrução mamária com retalho TRAM muscle sparing.

Em 2024, o Serviço de Fisioterapia do Hospital Erasto Gaertner celebrou 40 anos de existência, com a realização de um evento comemorativo em homenagem aos pioneiros da especialidade, com a participação de ex-residentes que fizeram parte da equipe ao longo dos anos.
Em reconhecimento ao valioso serviço prestado à instituição e, sobretudo, à sociedade, os fisioterapeutas
Cesar Costa e Woldir Wosiacki Filho receberam dos diretores executivos do Hospital uma homenagem pelo trabalho realizado desde o início das atividades da especialidade. As fisioterapeutas Rosemari Alves Pires e Marcieli Nascimento de Souza também foram homenageadas pelo profissionalismo e pelo talento dedicado ao HEG, como membros do corpo clínico.
Além de sua atuação no Hospital Erasto Gaertner, Woldir Wosiacki Filho integra a mesa diretora do Conselho Municipal de Saúde de Curitiba. Já Rosemari Alves Pires exerce a função de coordenadora da Comissão de Vigilância em Saúde no mesmo conselho.
Pelas contribuições para a construção da história dos Cuidados Paliativos no Paraná, o Conselho Regional de Medicina prestou homenagem a diversos integrantes do Erasto Gaertner. Além de médicos e profissionais de saúde, voluntários da Rede Feminina de Combate ao Câncer (RFCC - Curitiba) também foram reconhecidos pelo seu importante papel no apoio à causa. A cerimônia celebrou a dedicação e o compromisso de todos os envolvidos na missão de cuidar com dignidade e humanização.
Homenageados
Médicos:
Dr. Ewerton Dombek, Dr. Luiz Pedro Pizzatto, Dr. Roberto Bettega, Dr. Luiz Fernando Rodrigues, Dra. Maria Célia Broffman.
Enfermeiras:
Inez Gimenes, Danielle Sellmer, Cristiane Cristoff, Ozana de Campos.
Fisioterapeuta: Dr. Woldir Wosiacki Filho
Psicólogas:
Ana Claudia Wanderbroocke e Iolanda Galvão
Farmacêutica:
Vania Mari Salvi Andrzejevski
Voluntárias da RFCC:
Dirce Prandel e Maria Célia Nogueira Costa
Capelania:
Padre Arlindo e do Pastor Mário Sonntag.

Dr. Fabiano Luiz Erzinger, responsável pelo Serviço de Cirurgia Vascular do HEG, atuou como diretor de Publicações para a Sociedade Brasileira de Angiologia e Cirurgia Vascular (SBACV) - Regional do Paraná. Junto a esta instituição, ele foi o coordenador das Diretrizes Nacionais sobre Doença Arterial Periférica. Ele também contribuiu como membro das bancas das provas de título da especialidade e de obtenção de certificado da área de atuação em Angiorradiologia e Cirurgia.
Dr. Fabiano e da Dra. Camila Mazzoni fazem atendimentos toda sextafeira no ambulatório do HEG, na avaliação pré-operatória de riscos vasculares de pacientes com doenças oncológicas que tenham acometimento vascular. Também atuam na orientação e no atendimento dos pacientes oncológicos que desenvolvem doenças vasculares, como o tromboembolismo pulmonar e, principalmente, as tromboses tumorais intravasculares. Além disso, o Serviço atua no centro cirúrgico, interagindo com todas as especialidades cirúrgicas oncológicas, tanto nas intercorrências vasculares durante os atos operatórios quanto no auxílio e na prevenção de complicações vasculares nas cirurgias eletivas de grande porte.
Pela terceira gestão, Dr. Flavio Tomasich, do Serviço de Cirurgia Abdominal, ocupa o cargo de segundo vice-presidente nacional do Colégio Brasileiro de Cirurgiões, cujo Conselho está alocado no Rio de Janeiro (RJ). Nesta entidade de abrangência nacional, também é membro da Comissão de Cirurgia Oncológica e presidente da Comissão de Cirurgia Minimamente Invasiva e Cirurgia Robótica. Além disso, Dr. Flavio é um dos integrantes da Comissão de Cirurgia Minimamente Invasiva da Sociedade Brasileira de Cirurgia Oncológica; superintendente de saúde da Unimed Curitiba; e membro da diretoria da Associação Brasileira de Entidades Filantrópicas de Combate ao Câncer (Abificc), que engloba mais de 40 instituições.

O Dr. William Ribas e Targa, médico do trabalho e coordenador do Programa de Controle Médico de Saúde Ocupacional (PCMSO) do Hospital Erasto Gaertner, desempenha um papel fundamental na promoção da saúde e da segurança laboral na instituição há cinco anos. Além de sua vasta experiência na medicina ocupacional, Dr. William é membro ativo da diretoria da Associação Brasileira de Medicina Legal e Perícia Médica – Capítulo do Paraná.
Em 2024, o Dr. William realizou mais de 2.600 atendimentos no Serviço Especializado em Engenharia de Segurança e Medicina do Trabalho (SEMST). Seu trabalho contínuo visa a identificação de riscos ocupacionais, assegurando o cumprimento das normas vigentes de saúde e segurança do trabalho, com ênfase na imunização dos colaboradores e na implementação de estratégias para minimizar possíveis impactos à saúde.

Em 2025, o Dr. Fabricio Augusto Martinelli de Oliveira, do Serviço de Oncologia Clínica, foi homenageado pelos 25 anos de atuação no Hospital e pela dedicação aos pacientes oncológicos.
Em agradecimento pelos relevantes trabalhos prestados e às causas da instituição, o Dr. João Vitor Bacarin, do Serviço de Diagnóstico por Imagem, recebeu uma homenagem do Conselho de Administração da LPCC, em março de 2024. E, em reconhecimento por suas contribuições como preceptor de residência médica em Radiologia Intervencionista, o médico também foi homenageado pelo Hospital de Clínicas da UFPR.
Dra. Clarice Nana Yamanouchi e Dr. Luiz Sérgio Batista II, do Hospice Erasto Gaertner, passaram a integrar a Câmara Técnica de Cuidados Paliativos (Gestão 2024-2028) do Conselho Regional de Medicina do Estado do Paraná (CRMPR), auxiliando na elaboração de pareceres, resoluções e publicações da especialidade.
Para um mandato de dois anos, em outubro de 2024, o Dr. Bruno Bertoli Esmanhotto, do Serviço de Cuidados Paliativos do Hospice Erasto Gaertner, foi eleito presidente da Academia Brasileira de NeurologiaSeção Paraná.
Em reconhecimento à carreira na área de Cirurgia e Traumatologia Bucomaxilofacial, o Dr. Laurindo Moacir Sassi foi indicado e empossado na International College of Dentists (ICD), associação global de dentistas que reúne profissionais de todo o mundo.

Ao lado do programa Conscientizar+, em 2024 foram realizadas diversas ações em que o principal objetivo era a informação de qualidade e que ajuda a salvar vidas. Ao longo do ano, os médicos participaram de campanhas de conscientização e prevenção do câncer:
Com o apoio da Prefeitura de Guaratuba (PR), entre os dias 19 e 21 de janeiro, o HEG realizou uma ação de combate e prevenção ao câncer de pele. Estiveram presentes médicos do Serviço de Pele e Melanoma e enfermeiros especialistas em oncologia, que se instalaram na Praia Central da cidade, orientando a população sobre os perigos da doença, como prevenir e o que fazer em caso de suspeita.

Em alusão ao Dia Mundial sem Tabaco, celebrado em 31 de maio, o HEG realizou uma ação educativa com orientações aos colaboradores sobre os riscos do tabaco para a saúde, com a presença do Serviço de Cirurgia Bucomaxilofacial e outros profissionais do Hospital.

Em julho, as atividades e ações tiveram o foco de alertar sobre o câncer de cabeça e pescoço e incluíram: uma transmissão especial ao vivo no YouTube, com o Dr. Gyl Ramos, médico do Serviço de Cirurgia de Cabeça e Pescoço; divulgação de conteúdos informativos nos canais de comunicação; e uma dinâmica com pacientes, acompanhantes, visitantes e colaboradores. Além disso, o ônibus

Durante o Agosto Branco, o HEG realizou o 1º Simpósio de Câncer de Pulmão, para marcar o mês de conscientização sobre esse tipo de doença. O evento contou com a presença de especialistas na área, que promoveram um rico debate do C+ estava à disposição para realizar avaliação em casos mais específicos. A ação presencial foi conduzida pelo chefe do Serviço de Cirurgia Bucomaxilofacial do HEG, Dr. Laurindo Sassi, pela equipe de Bucomaxilofacial, bem como pelas enfermeiras especialistas e residentes da instituição.

sobre diversos aspectos, incluindo o rastreio, diagnóstico e tratamento. Entre os médicos participantes estavam: Dr. Danny Warszawiak, Dr. João Bacarin, Dra. Milena Kozonoe, Dr. Vinícius Preti, Dr. José Henrique Agner Ribeiro, Dra. Angela Dasenbrock, Dra. Maíria Neves e Dra. Thais Abreu de Almeida.
No Outubro Rosa, um evento especial destacou a importância da prevenção e do combate ao câncer de mama, promovido em parceria com a Secretaria da Mulher, Igualdade Racial e Pessoa Idosa e a Secretaria da Administração e da Previdência. A iniciativa reforçou a colaboração entre as entidades estaduais

e o Hospital Erasto Gaertner, unindo esforços em uma causa essencial. Um dos momentos marcantes foi o desfile das pacientes, que, além de elevar a autoestima, promoveu conscientização, prevenção e apoio às mulheres em tratamento.
No Novembro Azul, a campanha de conscientização sobre o câncer de próstata contou com mais uma edição do “Dia D” da prevenção, realizada em parceria com a Rede Feminina. A ação teve a participação dos Drs. Ronald Kool e Sanderson Cauduro, que compartilharam orientações sobre prevenção, diagnóstico precoce e cuidados com a saúde masculina.

Sob a coordenação do cirurgião-dentista Laurindo Moacir Sassi, chefe do Serviço de Cirurgia Bucomaxilofacial do HEG, a 36ª Campanha de Prevenção e Diagnóstico Precoce de Lesões Cancerizáveis de Boca contou, mais uma vez, com a parceria da Secretaria Municipal da Saúde de Curitiba e com apoio do Serviço de Cirurgia de Cabeça e Pescoço do HEG. Em 2024, a campanha se deu por meio de 13 projetos executados, com ações nas seguintes cidades: Araucária (PR), Curitiba (PR), Irati (PR), Morretes (PR), Paranaguá (PR), Pinhais (PR) e Joinville (SC).
Desde a primeira edição, ano após ano, a equipe leva informação até a população e orienta quem precisa de tratamento. Para além dos atendimentos realizados, o trabalho envolve educação preventiva, por meio de materiais informativos sobre autoexame e medidas profiláticas.







O projeto EVAT (Escala de Valoración de Alerta Temprana) integra as iniciativas do St. Jude Global, um programa do St. Jude Children’s Research Hospital voltado para fortalecer o atendimento oncológico pediátrico em diversos países. Seu principal objetivo é permitir a identificação precoce de sinais de agravamento clínico em crianças hospitalizadas, garantindo uma resposta rápida da equipe assistencial e melhorando os desfechos dos pacientes.
Em 2023, o Hospital Erastinho foi selecionado para participar desse projeto multicêntrico, tendo como líder local a Dra. Leisiane Bittencourt Cleve. O projeto-piloto foi implantado no setor de Transplante de Medula

Óssea (TMO) em maio de 2024 e, em janeiro de 2025, expandido para a enfermaria de Oncologia Pediátrica, ampliando seu impacto no hospital.
O Erastinho é o primeiro hospital no Brasil a adotar o EVAT inicialmente no setor de TMO, reforçando seu compromisso com a excelência assistencial e a inovação no cuidado pediátrico.
Merecem destaque os avanços nos procedimentos de terapia Car-T Cell, tratamento destinado a pacientes pediátricos e adultos jovens com leucemia linfoblástica aguda (LLA) de células B, refratária ou a partir da segunda recidiva. Em 2023, o Erastinho realizou o primeiro procedimento de terapia Car-T cell em criança no Brasil, fora do âmbito da pesquisa clínica. Até hoje, já foram realizados 8 procedimentos.

Em constante atualização, os médicos do Erastinho contribuíram para diversas pesquisas e publicações científicas ao longo do ano. Dra. Mara Albonei Dudeque Pianovski foi coautora de seis capítulos do Tratado de Pediatria, livro pela Editora Manole. Os títulos dos capítulos são: “Epidemiologia e diagnóstico precoce do câncer infantojuvenil”, “Tumores do sistema nervoso central”, “Tumores sólidos”, “Neoplasias no lactente”, “Emergências oncológicas” e “Indicação de sangue e hemocomponentes na criança com câncer”.
Com o artigo “29 anos de experiência em leucemia mielomonocítica juvenil e síndrome mielodisplásica: análise retrospectiva de 54 pacientes pediátricos”, a Dra. Mariane Farherr Caleffi Hoffman, em parceria com outros colegas, conquistou uma publicação no periódico americano Cancer Clinics Journal.
A Dra. Mara Pianovski, em parceria com o Comitê de Medicina de Precisão em Pediatria Oncológica da SOBOPE, foi coautora do artigo “Além dos ensaios clínicos: compreendendo os desafios e a eficácia do inibidor do receptor de tropomiosina neurotrófico na oncologia pediátrica do mundo real”, publicado no JCO Precision Oncology, periódico da

Sociedade Americana de Oncologia Clínica (ASCO). Entre suas produções técnico-científicas, destacam-se ainda a coautoria de um estudo sobre poluição ambiental e câncer, publicado no Jornal de Pediatria da Elsevier Editora, e outro artigo abordando os desafios do diagnóstico precoce do câncer infantil e adolescente, veiculado na Revista da Associação Médica Brasileira.
Dra. Ana Luiza de Melo Rodrigues e Dra. Mariane Caleffi fizeram parte do grupo de autores de uma análise retrospectiva da sobrevida e fatores associados em pacientes pediátricos com anemia aplásica submetidos a transplante alogênico de células-tronco hematopoéticas, publicada na revista Hematology, Transfusion and Cell Therapy.
Além disso, Dra. Ana Luiza Rodrigues, Dra. Andréia Rheinheimer, Dra. Antonella Zanette, Dr. Robson Coelho, Dra. Vilani Kremer e a enfermeira Andressa Taborda tiveram um artigo veiculado no Journal of Pediatric Surgery, compartilhando a experiência inovadora do uso de um cateter PICC de alto fluxo para aférese de células-tronco e linfócitos.
Como parte dos esforços dos profissionais do Erastinho para melhorar os cuidados pediátricos por meio da pesquisa clínica, a neurofisiologista Dra. Adriana Banzzatto Ortega participou das atividades do Estudo Clínico Steer ao longo de 2024. A investigação continua em 2025.
Unindo conhecimento e humanização, o Dr. Robson de Castro Coelho, do Serviço de Oncologia Pediátrica e diretor técnico do Erastinho, atuou como professor no curso de pós-graduação ofertado pela Escola de Palhaçaria Hospitalar (EPAH) em parceria com a Pontifícia Universidade Católica do Paraná (PUCPR). Esta é a primeira pós-graduação em palhaçaria hospitalar do mundo, um curso inovador que une arte e saúde de forma multidisciplinar.
Como professora, a Dra. Ana Luiza de Melo Rodrigues, do Serviço de Transplante de Medula Óssea, ministrou aulas nas disciplinas de Hematologia e Oncologia do curso de Medicina da Universidade Federal do Paraná.
Após a participação em cursos de aprimoramento do St. Jude Children’s Research Hospital nos últimos anos (Intensive Infection Control Course for Infection Preventionist, em 2023, e Infectious Diseases Training Seminar, em 2023 e 2024), a Dra. Laura de Almeida Lanzoni, do Serviço de Infectologia Pediátrica, iniciou o curso Pediatric Infectious Disease Clinical and Research Training focusing in Immunosuppressed Children, em março de 2024, com duração de um ano. O curso engloba atividades online e também uma etapa presencial. No mês de novembro de

2024, a Dra. Laura pôde acompanhar o Serviço de Infectologia do St. Jude Children’s Research Hospital, em Memphis, nos Estados Unidos, conhecendo a equipe médica da especialidade, incluindo a Dra. Miguela Caniza, diretora do Programa de Doenças Infecciosas do referido hospital. Foi um rico período de troca de experiências e conhecimentos.
A formatura do curso está prevista para março de 2025.
Dra. Mariane Farherr Caleffi Hoffman, do Serviço de Transplante de Medula Óssea, conquistou o título de Hematologista Pediátrica, com aprovação na prova aplicada pela Associação Médica Brasileira e Associação Brasileira de Hematologia e Hemoterapia.
Em parceria com profissionais de todo o Brasil, médicos e equipe multiprofissional do Erastinho continuaram fazendo parte da Aliança AMARTE, uma união de instituições hospitalares brasileiras com o propósito de aprimorar os resultados do tratamento oncológico para crianças e adolescentes, em colaboração com o St. Jude Children’s Research Hospital, instituição referência em oncologia pediátrica no mundo. A Dra. Mara Albonei Pianovski e o Dr. Robson de Castro Coelho integram o Comitê Gestor, o Dr. Adriano Lima, o Comitê Executivo, a Dra. Mariane Farherr Caleffi Hoffman coordena o Comitê de Cito-morfologia, a Dra. Maria Luísa Brito é a médica responsável pelo Registro de Dados na Aliança e a Dra. Laura de Almeida Lanzoni faz parte do Subcomitê de Infectopediatria.


Levando suas experiências como médicas onco-hematologistas pediátricas para além da atuação no Hospital Erastinho, a Dra. Mara Pianovski e a Dra. Ana Luiza de Melo Rodrigues participaram das atividades como integrantes do Comitê de Medicina de Precisão da Sociedade Brasileira de Pediatria (SOBOPE). Junto a esta entidade, a Dra. Ana Luiza também coordena o Grupo de Estudos de Leucemia Mieloide Aguda Infantil (GELMAI).
Junto ao departamento de Oncologia da Sociedade Brasileira de Pediatria, a Dra. Mara foi responsável pela produção de documentos científicos informativos para a sociedade. Entre os temas abordados estão: terapia nutricional em crianças com doença oncológica; diagnóstico precoce do câncer infanto-juvenil; retinoblastoma; linfomas; tumores ósseos malignos na criança e no adolescente; diagnóstico diferencial das neoplasias malignas abdominais; o que o pediatra precisa saber sobre câncer no adolescente; histiocitoses; como abordar náuseas e vômitos em pediatria e Setembro Dourado.
Em mais uma ação de conscientização, o Hospital Erastinho liderou as atividades em Curitiba da campanha “De olho nos olhinhos”, que contou com a participação de profissionais médicos, enfermagem, terapeuta ocupacional, especialistas da alegria, voluntárias

da RFCC, profissionais administrativos do Erastinho e do Marketing do Erasto Gaertner. Esta campanha, idealizada pelos jornalistas Tiago Leifert e Daiana Garbin, tem por finalidade informar a população sobre os sinais e sintomas do retinoblastoma, tumor intraocular mais frequente da criança e que, quando diagnosticado precocemente, pode ser curado, com preservação da visão.
LIGA PARANAENSE DE COMBATE AO CÂNCER
Mantenedora do Hospital Erasto Gaertner
Rua Dr. Ovande do Amaral, 201
Bairro Jardim das Américas
Curitiba-PR Redação: Thais Mocellin
Revisão: Camila Zaleski Alves de Queiroz e Keep Estratégia ESG
Design: Matheus Morozz